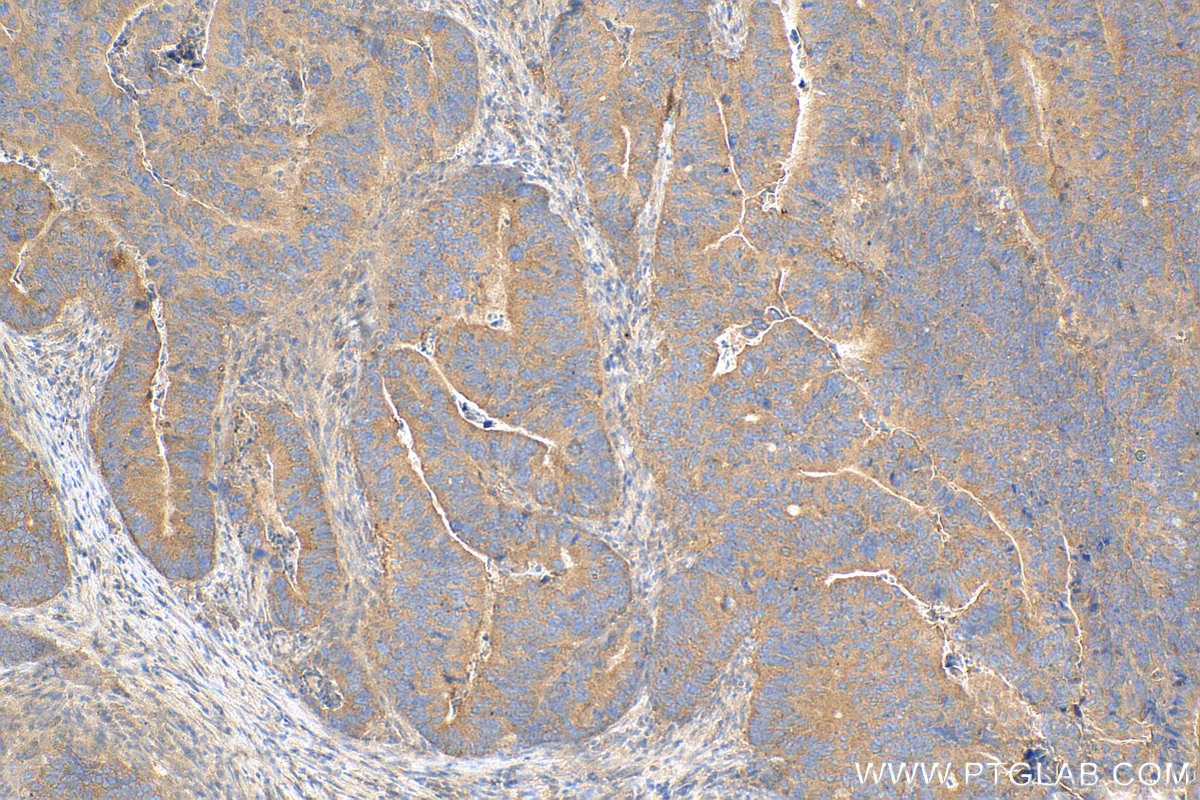
Immunohistochemistry (IHC) staining of human colon cancer tissue using mTOR Recombinant monoclonal antibody (81670-1-RR)

Product Information
81670-1-PBS targets mTOR in WB, IHC, IF/ICC, FC (Intra), IP, Indirect ELISA applications and shows reactivity with human, mouse, rat samples.
| Tested Reactivity | human, mouse, rat |
| Host / Isotype | Rabbit / IgG |
| Class | Recombinant |
| Type | Antibody |
| Immunogen |
CatNo: Ag28395 Product name: Recombinant human MTOR protein Source: e coli.-derived, PET28a Tag: 6*His Domain: 27-291 aa of NM_004958 Sequence: MSGLKSRNEETRAKAAKELQHYVTMELREMSQEESTRFYDQLNHHIFELVSSSDANERKGGILAIASLIGVEGGNATRIGRFANYLRNLLPSNDPVVMEMASKAIGRLAMAGDTFTAEYVEFEVKRALEWLGADRNEGRRHAAVLVLRELAISVPTFFFQQVQPFFDNIFVAVWDPKQAIREGAVAALRACLILTTQREPKEMQKPQWYRHTFEEAEKGFDETLAKEKGMNRDDRIHGALLILNELVRISSMEGERLREEMEEITQ Predict reactive species |
| Full Name | FK506 binding protein 12-rapamycin associated protein 1 |
| Calculated Molecular Weight | 289 kDa |
| Observed Molecular Weight | 250-289 kDa |
| GenBank Accession Number | NM_004958 |
| Gene Symbol | mTOR |
| Gene ID (NCBI) | 2475 |
| Conjugate | Unconjugated |
| Form | Liquid |
| Purification Method | Protein A purification |
| UNIPROT ID | P42345 |
| Storage Buffer | PBS only, pH 7.3. |
| Storage Conditions | Store at -80°C. |
Background Information
mTOR, also named as FRAP1, FRAP, FRAP2 and RAPT1, belongs to the PI3/PI4-kinase family. MTOR is a Ser/Thr protein kinase that functions as an ATP and amino acid sensor to balance nutrient availability and cell growth. MTOR is kinase subunit of both mTORC1 and mTORC2, which regulate cell growth and survival in response to nutrient and hormonal signals. mTORC1 is activated in response to growth factors or amino-acids. mTORC2 is also activated by growth factors, but seems to be nutrient-insensitive. mTORC2 seems to function upstream of Rho GTPases to regulate the actin cytoskeleton, probably by activating one or more Rho-type guanine nucleotide exchange factors. mTORC2 promotes the serum-induced formation of stress-fibers or F-actin. mTOR is phosphorylated at Ser2448 via the PI3 kinase/Akt signaling pathway and autophosphorylated at Ser2481. mTOR plays a key role in cell growth and homeostasis and may be abnormally regulated in tumors.